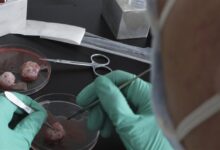

لهذه الاسباب يجب شرب القهوة مع الحليب

يقول العلماء، إن القهوة مليئة بمضادات الأكسدة التي تسمى البوليفينول، وقد ثبت أنها تقلل الالتهاب الذي يحدث عند استجابة الجسم للتهديدات مثل البكتيريا والسموم والصدمات، وكذلك يؤدي الالتهاب المزمن إلى الإصابة بمرض السكري وأمراض القلب والسرطان والتهاب المفاصل الروماتويدي.
ويشير بحث جديد أجري في جامعة كوبنهاغن، إلى أن تناول العناصر الغنية بالبوليفينول إلى جانب العناصر الغنية بالأحماض الأمينية، مثل الحليب، يجعل مضادات الأكسدة أكثر فعالية في تقليل الالتهابات.
وللتحقق من ذلك، طبق الباحثون الالتهاب الاصطناعي على الخلايا المناعية، وخلصوا إلى أن المزج بين البروتينات ومضادات الأكسدة يضاعف الخصائص المضادة للالتهابات في الخلايا المناعية.
وقال الباحثون إن النتائج تشير إلى أن القهوة مع الحليب لها تأثير مضاد للالتهابات، فالحليب غني بالبروتينات ويحتوي على جميع الأحماض الأمينية الأساسية التسعة التي يحتاجها الإنسان.
وينضم البحث الجديد إلى عدد كبير من الدراسات التي تربط القهوة بالعديد من الفوائد الصحية، بما في ذلك طول العمر، وتقليل فرص الإصابة بالاكتئاب أو مرض السكري.
وتم إجراء البحث في بيئة معملية، وليس في العالم الحقيقي، إذ يقوم الباحثون الآن بدراسة تأثير القهوة مع الحليب على الخلايا المناعية لدى الحيوانات قبل تطبيق الدراسة على البشر، وفق ما أوردته صحيفة ديلي ميل البريطانية.
مصدر الخبر
للمزيد Facebook